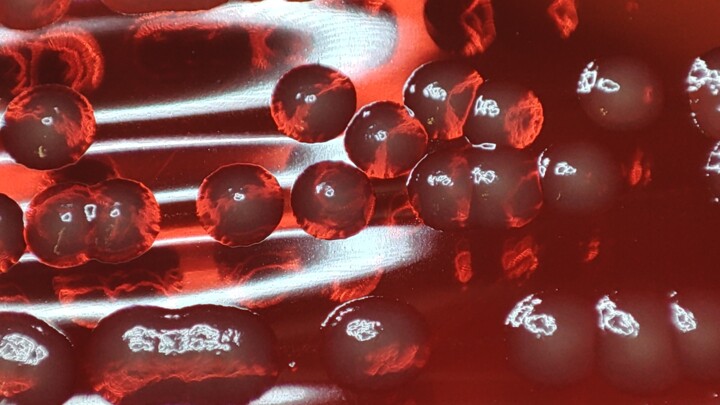

11 出售原始照片:
你在找出售原始照片吗?
探索艺术摄影的所有风格和技巧:当代摄影、街头艺术、抽象艺术、具象艺术、风景摄影、光绘、胶片摄影、数码摄影、黑白摄影...... ArtMajeur 旨在满足所有艺术敏感性并庆祝美在您身边 20 年,超过 360 万件当代艺术作品等您发现……或收藏!当代艺术摄影的世界参考。发现来自世界各地的当代艺术家的作品,用一流的方式装饰您的室内!单纯的艺术爱好者还是公认的收藏家?找到最喜欢的照片或快照,真正增强您的装饰效果。 ArtMajeur 为您提供世界上最好的当代摄影艺术家的原创作品、限量版和艺术版画。在 ArtMajeur 上,艺术照片由艺术市场的爱好者和专家挑选。我们为您精选时尚、屡获殊荣的知名摄影师的原创作品以及当代艺术领域的新兴价值,为您在线购买艺术照片提供指导和帮助。
Discover contemporary artworks on ArtMajeur
Contemporary art is a vibrant constellation of artistic expressions. This creative universe encompasses a wide array of mediums, from paintings, sculpture, and photography to drawing, printmaking, textile art, and digital art, each medium a star shining with its own distinct radiance. Artists use diverse supports and materials to bring their visions to life, such as canvas, wood, metal, and even innovative digital canvases for the creation of virtual masterpieces.
A contemporary painting, for instance, may weave its story through the masterful strokes of acrylic or oil, while a contemporary sculpture might sing its song in the language of stone, bronze, or found objects. The photographic arts capture and manipulate light to produce striking images, while printmaking employs techniques like lithography and screen-printing to produce multiples of a single, impactful image. Textile art plays with fabrics and fibers, whereas digital art pushes the boundaries of creation with innovative technology.
The allure of contemporary art lies in its boundary-pushing nature, its relentless quest for experimentation and its constant reflection of the evolving human experience. This boundless creativity, coupled with its strong social and personal commentary, makes every piece of contemporary art a unique emblem of its time, a mirror held up to the realities and dreams of our complex world. It whispers to us, moves us, provokes thought, and kindles a deep emotional response, stirring the soul of anyone willing to listen. It is, indeed, the language of emotions and ideas, spoken in the dialect of our era.

©2024 Nicolas-Monk.Gd
Origins and history of contemporary art
The story of contemporary art unfolds in the mid-20th century, marked by seismic shifts in artistic expression. Post-World War II, around the 1950s and 1960s, artists began experimenting beyond traditional confines, challenging the norms of what art could be. This revolutionary epoch birthed myriad new movements and artistic forms such as abstract expressionism, pop art, and minimalism. Paintings, once confined by realism, embraced abstraction, as artists used color and form to express emotions and ideas. Notable periods like the advent of pop art in the late 1950s and early 1960s saw artworks mimicking popular culture and mass media, reflecting society’s shifting focus.
The sculptural arts, too, witnessed a metamorphosis. Sculptors started to experiment with new materials and forms, often creating artworks that interacted with the viewer and the surrounding space, fostering a sense of engagement. Drawing, a timeless practice, also evolved, with artists incorporating innovative techniques and concepts to redefine its role in contemporary art.
Photography, a relatively new medium, emerged as a powerful tool in the contemporary art landscape. Born in the 19th century, it truly came into its own in the latter half of the 20th century, blurring the lines between fine art and documentation. Printmaking, a practice dating back to ancient times, saw renewed interest and experimentation with techniques like lithography, etching, and screen printing gaining prominence.
The realm of textile art expanded dramatically, as artists began to appreciate the versatility and tactile quality of fabric and fibers. Artists began using textiles to challenge the boundaries between fine art, craft, and design.
The dawn of digital technology in the late 20th century heralded a new age for contemporary art. Digital art emerged as artists started leveraging new technologies to create immersive, interactive experiences, often blurring the line between the virtual and the physical world.
Through these transformative periods, the essence of contemporary art has remained the same: a dynamic, evolving reflection of the times we live in, continually pushing boundaries and embracing the new, always questioning, always exploring.

©2023 Lovely Microbe
Evolutions of theses contemporary works in the art market
As we navigate through the 21st century, the dynamic landscape of contemporary art continues to evolve and expand, reflecting our ever-changing world. Contemporary paintings, once primarily confined to two-dimensional canvases, now embrace a multitude of forms and techniques, ranging from mixed media installations to digital creations, each piece a rich a weaving of thoughts, emotions, and narratives. Sculpture, too, has ventured far beyond traditional stone and bronze, with artists incorporating light, sound, and even motion, embodying the ephemerality and flux of the modern world.
Photography, in the hands of contemporary artists, has expanded its horizons, seamlessly blending with digital technology to create breathtaking imagery that challenges our perception of reality. Drawing, as well, has transcended the borders of paper, incorporating multimedia elements and exploratory techniques to redefine its role in the artistic discourse. Printmaking continues to flourish, with contemporary artists using traditional methods in innovative ways to deliver potent social and personal commentaries.
Textile art, once considered a craft, now holds a prominent place in the contemporary art world, with artists using it to explore issues of identity, tradition, and cultural heritage. Meanwhile, digital art, the newest member of the contemporary art family, has revolutionized the way we create and interact with art, presenting immersive experiences that blur the boundary between the virtual and the physical.
These diverse forms of contemporary art hold significant value in the current art market, not only due to their aesthetic appeal but also their ability to encapsulate and communicate complex ideas and emotions. Collectors, curators, and art lovers worldwide seek these works, drawn to their inherent dynamism, their innovative use of materials, and their eloquent expressions of our shared human experience. As a testimonial to our times, these contemporary artworks encapsulate the pulse of our society and the resonance of individual voices, forever etching our collective narrative into the annals of art history.
©2023 Lovely Microbe
Famous Contemporary Artists
As we delve into the vibrant realm of contemporary art, we encounter an array of artists who shape this dynamic field. Each a master in their medium - painting, sculpture, photography, drawing, printmaking, textile, or digital art - they push artistic boundaries, reflecting our era and challenging perceptions. Let’s explore these remarkable contributors and their groundbreaking works.
1. Gerhard Richter - Known for his multi-faceted approach to painting, Richter challenges the boundaries of the medium, masterfully oscillating between abstract and photorealistic styles. His works, whether featuring squeegee-pulled pigments or blurred photographic images, engage in a fascinating dialogue with perception.
2. Jeff Koons - A significant figure in contemporary sculpture, Koons crafts monumental pieces that explore themes of consumerism, taste, and popular culture. His iconic balloon animals, constructed in mirror-polished stainless steel, captivate with their playful yet profound commentary.
3. Cindy Sherman - An acclaimed photographer, Sherman uses her lens to explore identity and societal roles, particularly of women. Renowned for her conceptual self-portraits, she assumes myriad characters, pushing the boundaries of photography as a medium of artistic expression.
4. David Hockney - Hockney, with his prolific output spanning six decades, is a pivotal figure in contemporary drawing. His bold use of color and playful exploration of perspective convey an intoxicating sense of joy and an unabashed celebration of life.
5. Kiki Smith - An innovative printmaker, Smith’s work explores the human condition, particularly the female body and its social and cultural connotations. Her etchings and lithographs speak to universal experiences of life, death, and transformation.
6. El Anatsui - A master of textile art, Anatsui creates stunning tapestry-like installations from discarded bottle caps and aluminum scraps. These shimmering, flexible sculptures blend traditional African aesthetic with contemporary art sensibilities, speaking to themes of consumption, waste, and the interconnectedness of our world.
7. Rafael Lozano-Hemmer - A leading figure in digital art, Lozano-Hemmer utilizes technology to create interactive installations that blend architecture and performance art. His work, often participatory in nature, explores themes of surveillance, privacy, and the relationship between people and their environments.

©2023 Ekaterina Pogodina (Lexsa)
Notable contemporary artworks
The contemporary art landscape is a dynamic patchwork of diverse expressions and groundbreaking ideas, each artwork a unique dialog with its audience. Here are a selection of some renowned contemporary artworks, spanning various media such as painting, sculpture, photography, drawing, printmaking, textile art, and digital art, that have profoundly influenced this vibrant movement.
"Cloud Gate" by Anish Kapoor, 2006 - This monumental stainless steel sculpture, also known as "The Bean," mirrors and distorts the Chicago skyline and onlookers in its seamless, liquid-like surface, creating an interactive experience that blurs the line between the artwork and the viewer.
"Marilyn Diptych" by Andy Warhol, 1962 - An iconic piece of pop art, this silkscreen painting features fifty images of Marilyn Monroe. Half brightly colored, half in black and white, it reflects the dichotomy of celebrity life and its influence on popular culture.
"Rhein II" by Andreas Gursky, 1999 - This photographic artwork, a digitally-altered image of the Rhine River, is celebrated for its minimalist aesthetic. It strips the landscape to its bare essentials, invoking a sense of tranquility and vastness.
"Black Square" by Kazimir Malevich, 1915 - A revolutionary painting in the realm of abstract art, this piece, featuring nothing more than a black square on a white field, challenges traditional notions of representation, symbolizing a new era in artistic expression.
"Puppy" by Jeff Koons, 1992 - This giant sculpture, a West Highland Terrier blanketed in flowering plants, explores themes of innocence, consumer culture, and the interplay between high art and kitsch. It’s a delightful blend of traditional sculpture and garden craft.
"Re-projection: Hoerengracht" by Ed and Nancy Kienholz, 1983-1988 - A room-sized tableau representing Amsterdam’s red-light district, this work combines elements of sculpture, painting, lighting, and found objects. It engages viewers in a stark commentary on commodification and objectification.
"Untitled" (Your body is a battleground) by Barbara Kruger, 1989 - This photomontage, combining black-and-white photography with impactful text, explores issues of feminism, identity, and power. Its potent, confrontational message is a prime example of the power of text in contemporary visual art.
"For the Love of God" by Damien Hirst, 2007 - This sculpture, a platinum cast of a human skull encrusted with 8,601 diamonds, probes themes of mortality, value, and the human fascination with luxury and decadence. It’s a compelling blend of macabre and magnificence.
"Physical impossibility of Death in the Mind of Someone Living" by Damien Hirst, 1991 - This artwork, featuring a tiger shark preserved in formaldehyde, blurs the line between traditional sculpture and biological specimen. It prompts viewers to contemplate mortality and nature’s ferocity.
"One and Three Chairs" by Joseph Kosuth, 1965 - A piece of conceptual art, it presents a physical chair, a photograph of a chair, and a dictionary definition of a chair, thus exploring the relationship between language, picture, and referent in art.
These pieces, in their diversity, exemplify the rich tapestry of contemporary art, each piece a unique commentary on our world and a testament to the limitless potential of creative expression.
